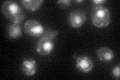
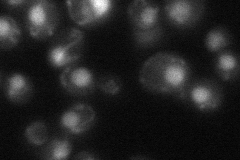
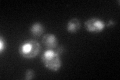

View description
DNA ligase found in the nucleus and mitochondria, an essential enzyme that joins Okazaki fragments during DNA replication; also acts in nucleotide excision repair, base excision repair, and recombination
Localization:
Intensity:
Fold change:
Significance:
-
C’ GFP library in SD
nucleus:mitochondria39.13 -
N' NOP1pr-GFP in SD

mitochondria104.985 -
N' TEF2pr-mCherry in SD

mitochondria121.356 -
N' NATIVEpr-GFP in SD
nucleus,mitochondria42.9125 -
N' TEF2pr-VC and Cyto-VN in SD

#N/A0 -
C’ GFP library in SD+DTT
nucleus.mitochondria38.50.98No -
C’ GFP library in SD+H2O2

nucleus.mitochondria38.610.98No -
C’ GFP library in Starvation Media

nucleus,mitochondriaN/AN/AYes -
C’ GFP library on the background of Pup2-DaMP

nucleus:mitochondria -
C’ GFP library on the background of CCT mutant

nucleus:mitochondria38.6130.986579No
